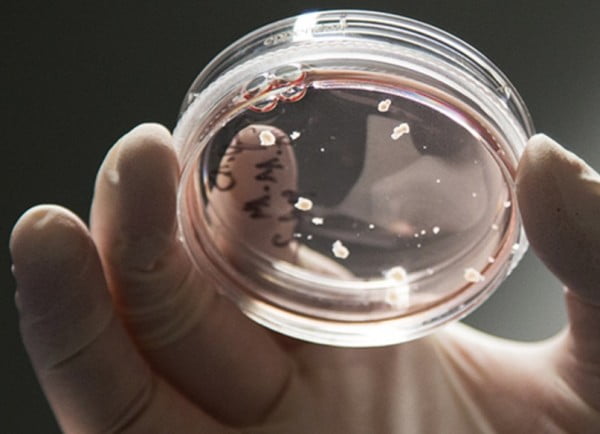
Brain Organoids

#İŞBİRLİĞİ
Beyin Organoid’leri / Üretilmesi Mümkün Olmayan Beyin Hücrelerine Mucizevi Bir Dokunuş
Ne zaman hayatımızda olacak: Hemen
Canlı nöronların yaşayan uzantıları, kök hücrelerden faydalanılarak laboratuvar ortamında canlandırılabiliyor. Bu gerçekten çok büyük bir gelişme; çünkü şimdiye kadar beyin üzerindeki araştırmaları fiziksel engellere takılan araştırmacılar, artık istedikleri şekilde çalışma yapıp, gözlem gerçekleştirebilecekler. Böylece çeşitli akıl hastalıkları, Bunama, Alzheimer ve diğer nörolojik bozukluklara çare üretilmesi hedefleniyor.
Institute of Molecular Biotechnology araştırmacılarından Madeline Lancaster’ın başı çektiği projede yer alan bilim insanları, basit beyinsel aktivitelerden Otizm’e kadar uzanan geniş bir skalada araştırma yapabilmeyi umuyorlar. Yetişkin bir insandan alınan, tek bir deri hücresi ile başlayan süreç, doğru biyokimyasal uygulamaların sonucunda önce Pluripotent (embriyonik gelişimin erken safhalarında, tüm bir canlıyı oluşturabilme yeteneğine sahip olan henüz farklılaşmamış hücreler için kullanılan bir tanımlama) kök hücreye, sonra da bir nörona dönüşüyor. Bu da daha önce yapılması imkansız olan bazı araştırmaların artık kolaylıkla yapılabilmesi demek. Artık, laboratuvar ortamında nöron üretebilen bilim insanları, beyin hücreleri arasındaki ilişkiyi ve çeşitli genetik modifikasyonlardan nasıl etkilendiklerini gözlemleyebilecek. Hatta, direk olarak araştırılmak istenen hastalığa sahip olan kişilerden alınan deri hücreleriyle üretilen nöronların gelişimi izlenerek, bu sürecin oluşumu hakkında daha önce edinilmesi mümkün olmayan bilgilere ulaşılabilecek.
Massachusetts General Hospital’dan Rudolph Tanzi ve Doo Yeon Kim, Viyana’daki Institute of Molecular Biotechnology’ten Jürgen Knoblich, MIT’den Rudolph Jaenisch ve John Hopkins’ten Guo-li Ming gibi ünlü araştırmacılar bu teknikle Otizm, Şizofreni ve Epilepsi gibi hastalıkların araştırmalarına çoktan başlamış durumda. Laboratuvar ortamında üretilen üç boyutlu nöronların karakteristiği, katmanları, yapısı ve ilişkisi incelenerek hastalıkların potansiyel nedenleri, gelişim süreçleri ve olası tedavileri üzerine etkin bir şekilde çalışılabilecek.






